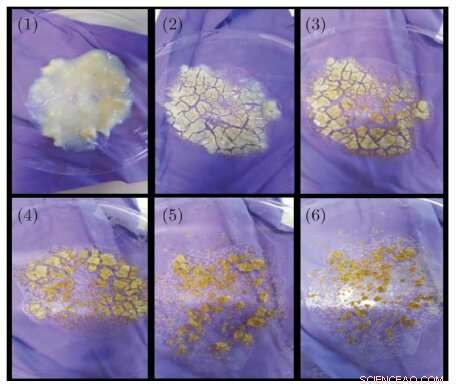
Microwave Synthesis of Simulated Cosmic Dust: A Controlled Approach

Successive steps during microwave drying of sol–gel: (1) the as-prepared gel, (2)–(6) after successive microwave exposures (900 W) of 1 min duration. Images shown are for Mg0.9Fe0.1SiO3, light brown colour of the dried product being due to Fe content. Credit: Diamond Light Source
Cosmic dust is the key to the chemical evolution of stars, planets, and life itself, but its composition is not well understood, and we can't currently collect samples for analysis. A few examples have arrived on Earth as interplanetary dust particles and comet dust, in meteorites, but their complicated history means they may not be representative.
Our primary methods of investigating the properties of cosmic dust, therefore, are astronomical observations and laboratory experiments on analogue materials. Cosmic dust broadly divides into soot-like carbon grains and the more abundant refractory silicate grains, both of which are ejected from dying stars.
Observations tell us that both amorphous and crystalline silicates form in the dust around red giant stars in varying proportions, but that the interstellar medium (ISM) contains only amorphous silicates. In work recently published in Astronomy & Astrophysics, a team of Diamond researchers led by Dr. Stephen Thompson demonstrated that microwave drying can be used to cheaply and easily produce amorphous Mg–Fe silicates. They then investigated their crystallisation by in situ thermal annealing and considered the results in the context of modelling dust grains in protoplanetary disks.
Dust is the first solid matter formed, and investigating cosmic dust is a very active field within astrophysics. We cannot replicate the formation conditions of cosmic dust here on Earth exactly, and no single method of producing analogue dust samples in the laboratory can simulate all of the dust we observe around stars and in the interstellar medium. However, by creating and characterising these samples, and comparing them to astronomical data to see where they are similar, and where they differ, we increase our understanding of the formation, composition and evolution of their cosmic counterparts
The sol-gel process is a chemical method used to produce solid materials from small molecules. Sol-gels have a consistency similar to hand cream and must be dried to form the dust samples. Air-drying takes about 24 hours and is time-consuming for researchers who wish to produce multiple samples.

Wide and small angle X-ray scattering facilities at diamond light source: panel A: beamline I11 3-circle powder diffractometer, showing the 90°-arc position sensitive detector used for the present work; panel B: beamline I22 small angle scattering instrument shown configured with the 9.7 m camera length used for the present work. Credit: Diamond Light Source
Another challenging aspect of producing analogue dust samples is the inclusion of iron, which—on Earth—tends to form rust (iron oxides) that isn't seen in space. Although we see evidence of iron in stars and planets, we don't see it in the interstellar medium. This is the 'missing iron' problem, and one possible explanation is that the iron being present in nanoparticles too small to see. Another is that iron is 'locked away' in silicate minerals, in quantities too low (less than 10%) to affect the spectral properties of the dust.
Using sol-gel to incorporate iron into the silicate structure requires special drying conditions and Dr. Thompson and his team had previously developed a vacuum drying process. However this took several days to complete from start to finish.
The researchers, therefore, investigated whether they could speed up the production of analogue samples, and produce iron-bearing silicate dust, using an off-the-shelf microwave oven.
The research team microwave-dried gels with and without iron, and investigated their properties using X-ray powder diffraction and total X-ray scattering on beamline I11, small-angle X-ray scattering on I22, and mid-IR FTIR spectroscopy. They compared the microwave-dried samples to samples produced from the same gel, but dried conventionally, using conventional in-air oven and vacuum furnace.
Much of the experimental work was carried out by Anna Herlihy during her Year in Industry placement at Diamond. Anna was in the middle of a degree at St. Andrews University and came to Diamond to investigate the production of amorphous nanoparticles. The cosmic dust research arose from her work, and—inspired by her experience—Anna has completed her degree and is now studying for a Ph.D. at Warwick University.

Schematic showing temperatures at which features for the crystalline phases appear in the in situ SXPD data for the microwave-dried silicates.
The results demonstrate that this is an excellent, quick, easy and cheap method for producing analogue dust samples. The team hope that it will be adopted by laboratory physicists elsewhere, but it could also have industrial applications, e.g. as a means of producing nanostructured materials.
The next stage of this research was to investigate what happens to the amorphous samples when they are heated. Observations show that old stars eject amorphous silicate minerals. Once in the interstellar medium, these eventually end up in star-forming regions and accumulate in protoplanetary disks, rotating disks of dense gas and dust around young stars. In the disk the dust grains heat up, and eventually crystallise to recognisable minerals. Protoplanetary disks thus represent the evolutionary stage between star birth and planet formation. We know that the disk is hotter closer to the star, and so understanding the temperature at which these minerals crystallise can tell us where they would be in the disk, and how long they were there.
The researchers found that adding even a small amount of iron to the silicate minerals dramatically increased the temperature at which they crystallised. So much so, in fact, that throughout most of the disk any iron-bearing silicates would remain amorphous, matching the observations by astronomers that mostly magnesium-rich minerals are present. The Diamond team also found small quantities of crystobalite (a high temperature SiO2 mineral) formed in the iron-free silicates. Similarly small quantities of SiO2 are also observed in protoplanetary disks and, crucially, were also found in the early solar system cometary materials recovered by the STARDUST sample return mission. Being the first planetesimal objects to have formed in the solar system, comets have long been considered as repositories of materials left over from our own solar system's formation, a process that would have begun in the Sun's protoplanetary disk.
For the Diamond team, this research is just the beginning. They will continue exploring their new microwave method, using it to produce dust samples with different compositions. Each sample gets us one step closer to understanding more about cosmic dust and how planetary systems form. Who would have guessed a kitchen microwave could help with that?